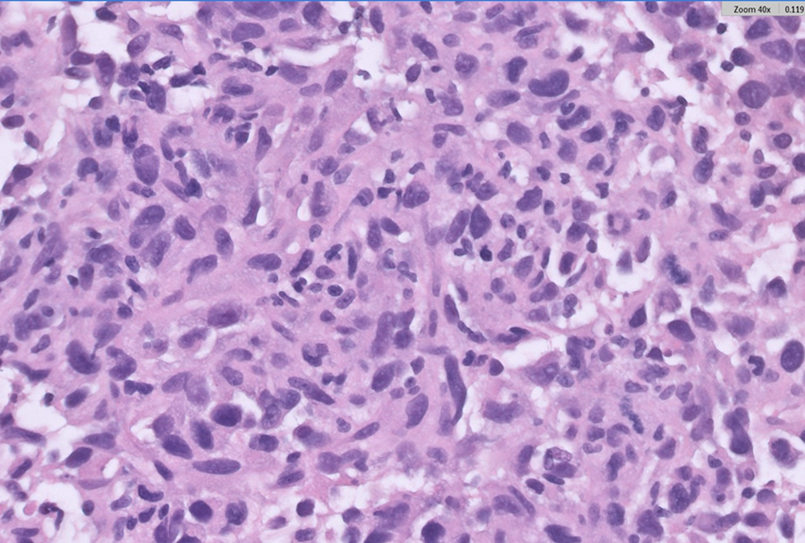

All published articles of this journal are available on ScienceDirect.
A Case of Primary Pulmonary Artery Intimal Sarcoma Leading to Right Heart Failure and Cardiogenic Shock: Diagnostic Challenges and Treatment Dilemmas
Abstract
Background
Pulmonary artery sarcoma (PAS) is a rare malignant tumor originating from the pulmonary arterial wall, often mimicking pulmonary thromboembolism. Echocardiography, computed tomography (CT), cardiac magnetic resonance imaging (MRI), and positron emission tomography-computed tomography (PET-CT) are crucial for early detection.
Case Presentation
A 35-year-old man presented with dyspnea, signs of pulmonary embolism, and right ventricular (RV) strain. Echocardiography suggested pulmonary embolism with a suspected mass in the right ventricular outflow tract (RVOT). Despite thrombectomy and thrombolysis, the filling defect persisted. The initial biopsy was negative for malignancy. Further imaging with CT, cardiac MRI, and PET-CT revealed a fluorodeoxyglucose (FDG)-avid mass extending from the RVOT into the main pulmonary artery, causing significant stenosis. Subsequent pleural and lung video-assisted thoracoscopic surgery (VATS) biopsies were also negative. After four months, a third CT-guided biopsy confirmed a high-grade spindle cell neoplasm. Retrospective examination of the thrombectomy specimen revealed a small focus of atypical spindle cells with an identical immunohistochemical profile. The tumor was inoperable, and chemotherapy was not initiated due to severe cardiac symptoms. The patient ultimately developed circulatory shock and succumbed to his illness.
Conclusion
This case highlights the importance of early diagnosis and intervention in PAS to prevent fatal outcomes. While histopathology remains the gold standard, initial negative biopsies delay treatment. In suspected cases, a thorough examination of thrombectomy specimens, along with ancillary studies, is critical. Advanced imaging techniques, including cardiac MRI and PET-CT, may provide sufficient diagnostic evidence to initiate treatment when biopsy results are delayed or inconclusive.
1. INTRODUCTION
Pulmonary artery sarcoma (PAS) is a very rare tumor with a prevalence of about 0.001-0.003%. [1, 2]. This high-grade malignant neoplasm was first reported in 1923 by Mandelstamm in an autopsy [3]. The tumor can occur in different age groups with an average age of 45-54 years. The age of incidence ranges from 2 months to 89 years [2-5]. PAS is divided into two types, intimal and luminal. The luminal type is extremely rare, and in general, pulmonary artery sarcoma refers to the intimal type of sarcoma [1, 4].
The pathogenesis of PAS remains poorly understood, with many aspects unexplored, including its origin site, primary lesion characteristics, the distinction between pulmonary artery intimal sarcoma and pulmonary artery luminal sarcoma, optimal treatment strategies, and recurrence patterns [5].
Patients usually present with shortness of breath, along with symptoms and signs of right ventricular failure [6]. This entity has often been misdiagnosed as pulmonary thromboembolism [2-6]. The prognosis of PAS is poor with metastasis to the brain, pancreas, adrenal gland, and lung [2]. Patients usually survive from 12-18 months after the appearance of symptoms. The 1-year and 2-year survival rates were 22 and 7%, respectively [2, 7].
PAS poses significant diagnostic challenges. This case highlights the complexities involved in diagnosing this rare tumor and underscores the critical role of advanced imaging techniques in guiding clinical decisions.
2. CASE PRESENTATION
A healthy 35-year-old man not known to have any comorbidities before was referred to our hospital with shortness of breath, signs of pulmonary embolism, and evidence of right ventricular strain.
Initial echocardiography showed features suggestive of pulmonary embolism and right ventricular strain. There was suspicion of a mass at the level of the right ventricular outflow extending into the main and right pulmonary arteries. Mechanical thrombectomy followed by 72 h of catheter-directed thrombolysis was performed. However, the pulmonary angiogram continued to show a persistent filling defect after 72 h of thrombolysis. Serial follow-up echocardiography studies during his hospital stay revealed a low-normal left ventricular systolic function and an ejection fraction of 54%. The right ventricle and right atrium were severely dilated, the right ventricular systolic function was severely reduced, and severe tricuspid regurgitation was seen. A large mass was seen occupying the right ventricular outflow tract (RVOT) and main pulmonary artery, causing subtotal obstruction with only minimal flow (Fig. 1A-D), (Suppl: Video 1).

(A) Parasternal short-axis view at the level of the aortic valve showing a mass in the right ventricular outflow tract (RVOT) and pulmonary artery (double arrows), along with a dilated right atrium (single arrows).
(B) Parasternal short-axis view at the level of the papillary muscles demonstrating a D-shaped septum in systole, indicative of elevated right ventricular systolic pressure (RVSP), with a dilated right ventricle (RV). Pericardial effusion is also visible.
(C) Apical four-chamber view showing dilated right-sided chambers with the presence of pericardial effusion.
(D) Apical four-chamber view with color Doppler revealing severe tricuspid regurgitation.
The patient was further investigated with computed tomography (CT), cardiac magnetic resonance imaging (MRI), and positron emission tomography-computed tomography (PET-CT). The CT scan showed a mass extending from the RVOT into the main pulmonary trunk, causing significant stenosis. PET/CT showed a fluorodeoxyglucose (FDG) avid lesion in the right ventricular outflow tract region extending to the right main pulmonary artery and the lobar arteries (Fig. 2A-D). Cardiac MRI showed an enhancing filling defect within the RVOT, main, and right pulmonary arteries, suggestive of a neoplastic process, most probably a pulmonary artery angiosarcoma. Signs of right heart volume and pressure overload were also seen (Fig. 3A-D). The patient also had a right-sided pleural effusion.
The thrombectomy specimen sent for histopathology was reported as negative for malignancy. Later, a pleural biopsy, lung biopsy, and pleural fluid cytology were performed and reported as negative for malignancy. A repeat CT-guided transthoracic biopsy was done 4 months after the initial presentation. Microscopy showed fragments of fibro-adipose tissue with a high-grade neoplasm arranged in sheets (Fig. 4). The tumor cells were spindled to ovoid and exhibited moderate eosinophilic cytoplasm, pleomorphic hyperchromatic nuclei, and prominent nucleoli. A mitotic count of 7/10 high-power fields (hpf) was noted, along with atypical mitotic figures. The tumor showed a variable amount of chronic inflammatory cells. The tumor cells were strongly

(A) Maximum intensity projection (MIP) FDG PET/CT of the thorax demonstrates heterogeneous FDG avidity overlying a branching linear structure in the right side of the mediastinum.
(B) Axial PET image shows an intensely FDG-avid linear lesion in the superior right mediastinum, with a maximum standardized uptake value (SUVmax) of 12.3.
(C) Axial CT pulmonary angiography (CTPA) reveals an expansile filling defect occupying the entire luminal diameter of the main pulmonary artery, extending into its proximal branches.
(D) Axial PET/CT image precisely localizes the heterogeneously hypermetabolic mass to the main pulmonary artery and its proximal branches. Additionally, extraluminal FDG activity is observed, suggesting possible tumoral extension.
and diffusely positive for Vimentin and MDM2, Murine Double Minute 2 homolog. Alpha SMA, Alpha Smooth Muscle Actin, Desmin, and Calponin showed very weak focal positivity. CD31, CD34, Factor VIII, HHV8 Human Herpesvirus 8, S100, PanCK Pan-Cytokeratin, Cam5.2 Cytokeratin antibody clone, Synaptophysin, Chromogranin, and TTF-1 Thyroid Transcription Factor-1 were found to be negative. The Ki-67 proliferation marker proliferation index was 70% (Fig. 5). The morphology and immunohistochemical profile, in correlation with CMR (cardiac magnetic resonance), were compatible with a diagnosis of pulmonary artery intimal sarcoma. The tumor was positive for PD-L1 Programmed Death-Ligand 1. A second review of the initial thrombectomy specimen was performed. It revealed a small focus of atypical spindle cells that were positive for SMA and MDM2, confirming the presence of a small tumor focus entrapped within the blood clot (Fig. 6).

Cardiac MRI Sequences for Mass Characterization.
(A): Cine-SSFP (Cine-steady state free precession) sequence at the level of the great vessels, showing an iso-heterogeneous mass in the main pulmonary artery extending from the right ventricular outflow tract (RVOT). (B): Perfusion sequence at the level of the great vessels, demonstrating hyperenhancement of the mass. (C): T1-weighted sequence at the level of the great vessels, revealing an iso-hyper heterogeneous mass in the main pulmonary artery extending from the RVOT. (D): Late Gadolinium Enhancement sequence at the level of the great vessels, showing an iso-hyper heterogeneous mass in the main pulmonary artery extending from the RVOT. Mass indicated by Asterix.
Hematoxylin and eosin (H&E, 400×) staining of the CT-guided biopsy specimen shows pleomorphic spindle to ovoid tumor cells with frequent mitotic figures and scattered chronic inflammatory cells.

Immunohistochemical (IHC, 200×) staining demonstrates tumor cells positive for Murine Double Minute 2 homolog MDM2 and Desmin, while negative for CD31. Ki-67 staining reveals a high proliferation index.

Initial thrombectomy specimen with blood clot and a small focus of atypical spindle cells (HE, 200x), positive for Murine Double Minute 2 homolog MDM2 and Smooth Muscle Actin SMA (IHC, 200x).
The mass was increasing in size and was deemed inoperable by the cardiothoracic surgical team due to its large size, infiltration into critical structures of the great vessels, and the patient's critical cardiac condition, including severely elevated pulmonary artery pressure, severe right ventricular failure, and near-circulatory shock. Unfortunately, the patient's condition deteriorated during his admission, and he eventually developed circulatory shock related to right ventricular outflow tract obstruction and succumbed to his illness. The final clinical stage of the tumor was T3, NX, M0, indicating local tumor invasion without confirmed regional lymph node status and no distant metastasis. The time from initial diagnosis of pulmonary embolism to death was approximately 8 weeks, while the time from the definitive diagnosis of pulmonary artery sarcoma to death was around 4 weeks.
3. DISCUSSION
PAS is a rare and aggressive malignancy, with fewer than 400 cases reported globally [8, 9]. Our patient's presentation with shortness of breath and right ventricular strain was consistent with prior reports in which pulmonary artery sarcoma was often misdiagnosed as pulmonary
thromboembolism [6, 10, 11]. Histologically, PAS shows proliferation of spindle or epithelioid
cells in a myxoid background with a high mitotic index and varying degrees of cellular
pleomorphisms. PAS has been reported to develop from pluripotent mesenchymal cells [12]. As a result, it may exhibit multiple lines of differentiation, such as leiomyosarcoma, spindle cell sarcoma, rhabdomyosarcoma, chondrosarcoma, osteosarcoma, or angiosarcoma [12].
In our case of pulmonary artery sarcoma (PAS), immunohistochemistry showed weak focal positivity for Alpha-SMA, Desmin, and Calponin, reflecting its pluripotent histogenesis. The tumor demonstrated strong, diffuse positivity for Vimentin and MDM2; while Vimentin is non-specific, MDM2 expression is more diagnostically significant [6, 9, 12]. Although MDM2 gene amplification is essential for confirming PAS, limited tissue availability led us to use MDM2 immunohistochemical positivity as a surrogate. PAS typically lacks cytokeratin (CK) expression, helping to distinguish it from sarcomatous carcinoma. Variable expressions of vascular markers, such as CD31, CD34, and Factor VIII, may occur; however, in our case, their absence made angiosarcoma unlikely. The morphological, immunohistochemical, clinical, and radiological features supported the diagnosis of PAS [13, 14].
Right-sided heart failure and cardiogenic shock are life-threatening complications in PAS, largely due to obstruction of the right ventricular outflow tract (RVOT) by the tumor mass [15]. In our case, the obstructing tumor caused severe dilation of the right ventricle and tricuspid regurgitation, ultimately leading to compromised cardiac output and circulatory collapse. This is consistent with the hemodynamic burden imposed by PAS, in which RVOT obstruction results in increased afterload on the right ventricle, progressing to right ventricular failure, cardiogenic shock, and death if left untreated. The rapid progression to shock in this patient underscores the need for early intervention before irreversible right heart failure develops [16, 17].
Diverse biopsy procedures have been utilized for diagnosing PAS, which include CT-guided transthoracic biopsy, endobronchial ultrasound-guided transbronchial needle aspiration/biopsy (EBUS-TBNA/B), and percutaneous endovascular catheter biopsy [18]. In diagnostically challenging cases of PAS, the choice of biopsy technique is critical. CT-guided transthoracic biopsy, while widely used, may be limited by accessibility of the lesion, particularly in centrally located or intravascular tumors. In contrast, endovascular catheter biopsy allows direct sampling of intraluminal lesions via a percutaneous vascular approach, which may reduce sampling error in tumors confined to the vessel lumen. Fujii et al. [18] demonstrated successful diagnosis of PAS using endovascular biopsy, highlighting its value when extravascular extension is minimal. However, this technique requires specialized expertise and carries risks such as bleeding or vessel injury. In our case, CT-guided biopsy was preferred due to prior negative histology, the presence of pleural and parenchymal involvement, and logistical considerations [18, 19].
Also, PAS is often adherent to or covered by thrombus or necrotic tissue, which increases the chances of sampling error [19]. Our patient had concurrent pulmonary thromboembolism masking the tumor. This was further confirmed retrospectively upon re-examination of the initial thrombectomy specimen, which revealed a very small, single focus of atypical spindle cells embedded within the blood clot. The spindle cells were positive for SMA and MDM2 on immunohistochemical examination. Hence, if the clinical and radiology findings are highly suspicious, our recommendation is to submit the entire tissue for histopathological examination. Examining multiple levels of the paraffin sections will help detect scant tumor tissue. Immunohistochemical panels, including Desmin, SMA, CD31, and MDM2, are recommended for confirmation.
The diagnostic challenges in such cases are critical, as time plays a pivotal role in determining outcomes, particularly before the development of significant circulatory obstruction. Employing multiple imaging modalities and diverse biopsy techniques can significantly enhance diagnostic accuracy in these patients. Several factors may contribute to negative biopsy results, including inadequate sampling, technical challenges due to the tumor's location, or masking by a thrombus. While biopsy and histology remain the gold standard for cancer diagnosis, early intervention is often crucial in cases of PAS, especially when the tumor compromises cardiac function. Delaying treatment while awaiting multiple biopsies can be life-threatening. Advanced imaging techniques, such as cardiac MRI and PET scans, offer critical insights and may support an early diagnosis even when biopsy results are inconclusive or delayed [20].
Gatti et al. emphasize the importance of a preliminary non-invasive diagnostic work-up in evaluating cardiac masses [21-23]. Cardiac MRI offers detailed anatomical and tissue characterization, enabling precise identification of structural abnormalities. PET-CT, on the other hand, provides critical functional information, as it evaluates the metabolic activity of lesions, which is crucial for distinguishing malignant from benign masses. In this case, the FDG-avid lesion in the RVOT serves as a prime example of how PET-CT complements the anatomical detail provided by MRI, allowing for a more comprehensive understanding of the tumor's behavior. Together, these imaging modalities provide a robust foundation for initiating timely treatment when histological confirmation is not immediately available [24].
18FDG-PET/CT combines metabolic and anatomical imaging to improve diagnostic accuracy, particularly in differentiating malignancies. It can be interpreted visually or semi-quantitatively using the standardized uptake value (SUVmax), which complements clinical judgment. Although PET and MRI are increasingly used in management-based diagnosis, their standalone use is not yet validated; biopsy remains the gold standard due to its superior sensitivity and specificity. Some systematic reviews suggest potential in combining PET and MRI for diagnosis; however, this approach requires further research and randomized trials, particularly when integrated with clinical assessment and patient presentation [25].
A recent pooled analysis by Kashizaki et al. [5] involving 643 patients with primary pulmonary artery sarcoma (PPAS) emphasized the diagnostic value of 18F-FDG PET/CT in distinguishing PPAS from pulmonary thromboembolism (PTE), with suggestive PET/CT findings in 93.9% of cases and definitive diagnosis achieved in 98.2% before death. This supports the relevance of advanced imaging modalities in challenging cases like ours, where conventional assessment may not be sufficient to differentiate malignancy from thrombosis [5].
In critically ill patients with significant hemodynamic compromise, proceeding with surgery based on imaging findings, followed by histopathological confirmation from resected tissue, may provide the best chance of improving outcomes. A strategy that combines imaging with clinical judgment enables more rapid diagnosis and intervention, thereby minimizing the risks associated with delayed treatment [18].
Although complete surgical resection has shown some promise in improving survival [26], our patient was deemed inoperable due to the extent of cardiac involvement and the hemodynamic instability caused by the RVOT obstruction. In advanced cases like this, surgical resection is often declined. Also, chemotherapy and radiotherapy were not viable options due to the heart's compromised function, which significantly limits treatment options and contributes to the poor prognosis [12].
The survival in patients with PAS without treatment is only 1.5 months [27]. Blackmon et al. reported that the median survival was prolonged to 36.5 Añ 20.2 months with complete surgical resection versus 11 Añ 3 months with incomplete surgical resection [26]. The study also reported that the median survival was 24 Añ 8 months for those receiving multimodal treatment, compared with 8 months for those undergoing surgery alone. Some studies showed that the median survival of patients who were inoperable due to disease progression (progressive right heart failure) was only 6 weeks, while the survival time of patients with surgical resection can be up to 3 years [2, 7, 23].
Pathological evaluation, particularly assessing PD-L1 expression, may help guide treatment decisions in sarcomas. Although PD-L1 positivity has been reported in over 50% of sarcomas, with expression rates varying by subtype, it remains largely untested in rare entities, such as pulmonary artery and cardiac sarcomas, due to their rarity and aggressive course. Recent data suggest that a subset of cardiac sarcomas may respond to immune checkpoint inhibitors, with response rates depending on histologic subtype [28, 29]. This highlights the potential role of incorporating immunohistochemical profiling into treatment planning for select patients.
The rapid clinical deterioration as observed in the present case underscores the need to consider initiating treatment based on imaging findings. Relying on advanced imaging techniques, such as cardiac MRI and PET-CT, in such cases could be a reasonable approach to avoid delays in treatment. This strategy may help prevent rapid tumor progression or further decline in the patient's condition and warrants further consideration in clinical practice [30].
CONCLUSION
PAS is a rare and aggressive malignancy that poses significant diagnostic and therapeutic challenges. Delay in diagnosis and treatment can result in rapid tumor progression and worsening hemodynamic compromise, as observed in the present case. While biopsy remains the gold standard, advanced imaging techniques such as cardiac MRI and PET-CT may provide sufficient evidence to initiate treatment in critically ill patients when biopsy results are negative. A multidisciplinary approach, emphasizing timely diagnosis and intervention, is essential for improving outcomes in these patients.
FUTURE PERSPECTIVES
(1) Role of Advanced Imaging: Cardiac MRI and PET-CT are invaluable tools in the evaluation of cardiac masses, providing detailed anatomical, tissue characterization, and metabolic activity insights that can guide clinical decision-making when biopsy results are delayed or inconclusive.
(2) Significance of Early Intervention: Rapid disease progression and hemodynamic compromise in patients with PAS highlight the importance of prompt diagnosis and treatment initiation. A multidisciplinary approach may be necessary to evaluate imaging findings and avoid delays in treatment.
(3) When to Rely on Imaging: In critically ill patients with life-threatening conditions, initiating treatment based on imaging findings could be justified. This approach can prevent worsening cardiac dysfunction or circulatory collapse while awaiting histopathological confirmation.
DECLARATIONS
No AI-assisted tools were used by any of the authors in the preparation of this work.
AUTHORS' CONTRIBUTIONS
A.A.A, Y.A.B, and M.A.B contributed to data collection and critical review of the manuscript. B.I, H.H, and W.D contributed equally to conceptualization, drafting, reviewing, and editing the manuscript. A.B was responsible for conceptualization, data interpretation, supervision, writing the original draft, and final approval of the manuscript. All authors read and approved the final version of the manuscript.
LIST OF ABBREVIATIONS
| ACS | = Acute Coronary Syndrome |
| CAM 5.2 | = Cytokeratin CAM 5.2 |
| CD | = Cluster of Differentiation |
| CMR | = Cardiac Magnetic Resonance |
| CT | = Computed Tomography |
| CTRCD | = Chemotherapy-Related Cardiac Dysfunction |
| EBUS-TBNA/B | = Endobronchial Ultrasound-Guided Transbronchial Needle Aspiration/Biopsy |
| EF | = Ejection Fraction |
| FDG | = Fluorodeoxyglucose |
| GLS | = Global Longitudinal Strain |
| HPF | = High-Power Field |
| HHV8 | = Human Herpesvirus 8 |
| ICI | = Immune Checkpoint Inhibitor |
| Ki-67 | = A Cellular Proliferation Marker |
| MACE | = Major Adverse Cardiac Events |
| MDM2 | = Mouse Double Minute 2 |
| MRI | = Magnetic Resonance Imaging |
| PanCK | = Pancytokeratin |
| PAS | = Pulmonary Artery Sarcoma |
| PD-L1 | = Programmed Death-Ligand 1 |
| PET-CT | = Positron Emission Tomography-Computed Tomography |
| RVOT | = Right Ventricular Outflow Tract |
| SMA | = Smooth Muscle Actin |
| TTF-1 | = Thyroid Transcription Factor 1 |
| VATS | = Video-Assisted Thoracoscopic Surgery |
CONSENT FOR PUBLICATION
Written informed consent was obtained from the patient's relative to publish this paper.
AVAILABILITY OF DATA AND MATERIALS
The data supporting the findings of the article are available from our institutional TomTec and PACS system. The original contributions presented in the study are included in the article. Further inquiries can be directed to the corresponding author.
ACKNOWLEDGEMENTS
Declared none.

